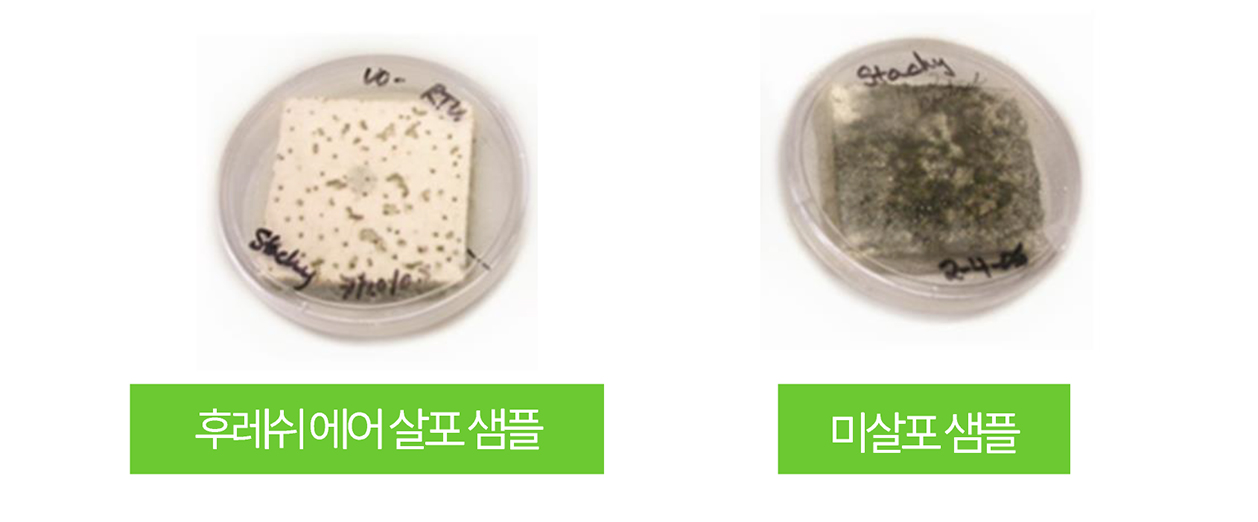

엔글로벌만의 에멀젼 이산화염소

에멀젼 이산화염소
일반 이산화염소와 달리 이산화염소를 에멀젼화 (캡슐코팅)하여 탈취 지속 능력과 보관 용이성을 상승시켰습니다.

살균효과
● Clo2 중 산소원자에 의한 산화작용, Clo2는 고도로 선택적인 산화 작용을 통해서
세포의 필수 아미노산과 반응해서 박테리아, 바이러스 및 변성 단백질을 제거합니다.
● 반면, 다른 유기 물질과는상대적으로 반응하지 않음으로써 Clo2의 필요한 수치를 줄여줍니다.

● 후레쉬 에어는 구성 성분의 입자를 나노사이즈까지 줄임으로써, 살균 능력을 획기적으로 증가 시켰습니다.
(Hard or Porous Surface에 신속하게 퍼지고 깊숙이 침투됨)
● 후레쉬 에어는 특수 기술로 안정화 시킨 것이므로 일반적인 보관 조건에서
제품 효능이 98% 이상으로 장기간 지속 가능합니다.
후레쉬에어는 그람 양성 및 음성 박테리아 99.999%가 사멸됩니다.

후레쉬에어를 살포했을 경우(왼쪽)와 뿌리지 않은 경우 (오른쪽)에 대하여 7개월 경과 이후 결과를
확인해 본 결과 곰팡이가 발생하지 않음을 확인할 수 있습니다.
후레쉬에어 살균 대상 병균
▶ Virus: 신종플루(H1N1), influenza A, 슈퍼 박테리아 (MRSA, VRE)
▶ Norovirus, Salmonella, Canine Parvovirus, 레지오넬라, 대장균 등
▶ 곰팡이균: Aspergillus niger, Yeast, Spore 등

▶ 항생 물질에 대해 내성을 가진 세균의 진화
→ 항생제 남용이 주 원인
※ VRSA 감염으로 인한 사망자 수는 현재 에이즈 감염으로 인한 사망자 수보다 많음
왜 후레쉬에어인가요?
농산물의 변질 요인이 복합적인데 반하여 시중에서 유통되는 수분이나 가스 흡착만으로는
신선도를 유지하기 힘들었습니다. 기존의 실리카겔이나 에틸렌 가스, 이산화탄소 흡착제와 같은
선도 유지제가 시장의 주류를 형성하고 있지만 미약한 효과때문에 살아있는 생물인
농작물에는 사용을 할 수 없었습니다.
농산물 변질의 주요 요인 중 하나는 미생물의 발효로,
미생물인 세균과 곰팡이를 억제하는 엔글로벌의 선도유지제 후레쉬 에어는
WHO A-1 등급을 받은 먹는 물 소독제 이산화염소를 기본으로 하는 제품입니다.
이산화염소 가스 방출량을 미세 조절하여 일정 시간 동안 일정 농도의
이산화염소가 서서히 방출될 수 있도록 겔 (점성이 있는 액체-고체 중간의 상태)화로
안정화 시킨 제품으로
미생물 억제에 탁월한 효과가 있습니다.

농산물 이외 많은 분야에 적용 가능하며, 앞으로 1인 가구의 증가와 소포장 용기 유통 및 택배 생활이
더욱 증가할 트렌드를 고려할 때 제품 유통 시 패키지 내부에 적용한다면 화훼 (절화 수·출입)를 포함하는
농산, 임산, 축산, 수산, 백색 육가공 및 식품 제품 등의 미생물 억제, 예방, 유통, 저장, 보관,
먹거리 안전에
획기적인 역할이 기대되는 제품입니다.
주요 사용처는 내수 농산물 유통 및 수출입 과일에 적용 가능합니다.
실제 사용 사례
